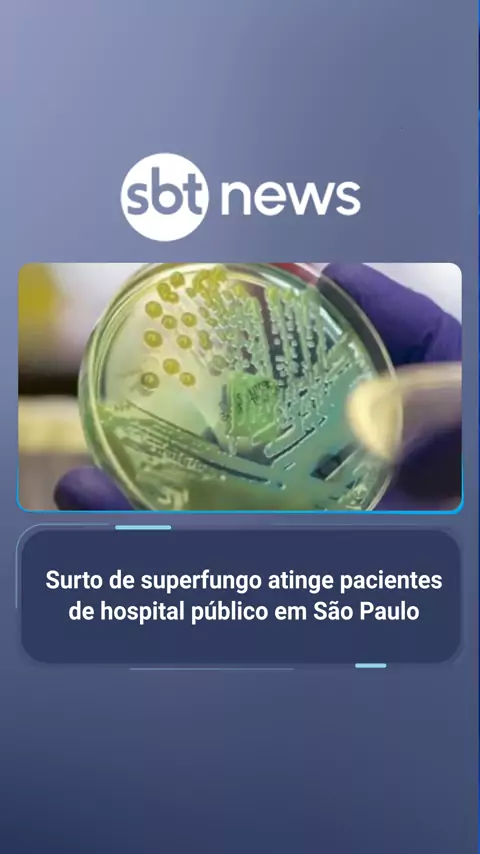

Follow

1.2K

119

256
SBT News
O Hospital do Servidor Público Estadual, localizado na zona sul de São Paulo, enfrenta um surto do “superfungo”. Pelo menos 14 pacientes já testaram positivo para o patógeno desde o começo do ano, quando um idoso de 73 anos morreu devido à infecção. Os casos são de indivíduos colonizados, isto é, quando há a presença do fungo no corpo, porém não ativado. | #sbtnews #notícias #saude #superfungo #saopaulo #hospital
More
Comment
Cancel
Send